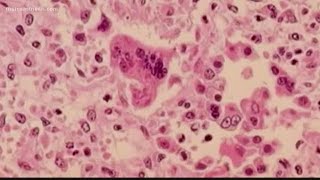

Health officials encourage measles vaccinations as outbreak spreads video
Online izle ve mp4 mp3 formatlarinda yukle

Videonun muddeti: 2:26
Health officials encourage measles vaccinations as outbreak spreads videosu mp4 ve mp3 yuklemek ucun hazirdir
Diqqet! Siz Mp4 yukle ve ya Mp3 yukle duymesine basdiqdan sonra eger sistem sizi reklam sehifesine atarsa o zaman derhal geri qayidib emeliyyati tekrar edin ve faylin yuklemek ucun hazir olmasini gozleyin
Videodan Mp4 Yukle
Videodan Mp3 Yukle-1
Videodan Mp3 Yukle-2
Oxshar Axtarishlar
 Health officials encourage measles vaccinations as outbreak spreads
Health officials encourage measles vaccinations as outbreak spreads Health officials urge vaccinations as Measles outbreak spreads
Health officials urge vaccinations as Measles outbreak spreads Health officials warn of potential measles outbreak, encourage parents to get children vaccinated
Health officials warn of potential measles outbreak, encourage parents to get children vaccinated Health officials expect spread of measles
Health officials expect spread of measles Health officials encourage travelers to get MMR vaccine as measles cases spread nationwide
Health officials encourage travelers to get MMR vaccine as measles cases spread nationwide Health officials discuss importance of vaccines after measles outbreak at child care center
Health officials discuss importance of vaccines after measles outbreak at child care center Health officials issue warning about measles outbreak
Health officials issue warning about measles outbreak Health officials encouraging measles vaccine
Health officials encouraging measles vaccine Measles epidemic continues to grow, health officials up pro-vaccine efforts
Measles epidemic continues to grow, health officials up pro-vaccine efforts
Video Mp4 Mp3Azwap.Biz
Azwap.Biz 2021-2023


 Health officials encourage measles vaccinations as outbreak spreads
Health officials encourage measles vaccinations as outbreak spreads Health officials urge vaccinations as Measles outbreak spreads
Health officials urge vaccinations as Measles outbreak spreads Health officials warn of potential measles outbreak, encourage parents to get children vaccinated
Health officials warn of potential measles outbreak, encourage parents to get children vaccinated Health officials expect spread of measles
Health officials expect spread of measles Health officials encourage travelers to get MMR vaccine as measles cases spread nationwide
Health officials encourage travelers to get MMR vaccine as measles cases spread nationwide Health officials discuss importance of vaccines after measles outbreak at child care center
Health officials discuss importance of vaccines after measles outbreak at child care center Health officials issue warning about measles outbreak
Health officials issue warning about measles outbreak Health officials encouraging measles vaccine
Health officials encouraging measles vaccine Measles epidemic continues to grow, health officials up pro-vaccine efforts
Measles epidemic continues to grow, health officials up pro-vaccine efforts